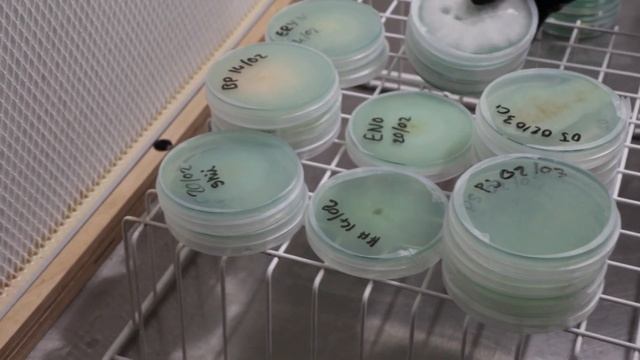
🍄 TITOUAN vous dévoile les SECRETS de son LABORATOIRE de MYCICULTURE - Épisode 2 смотреть онлайн

Автор: Весёлые опыты с наукой Страница 4

selena gomez love song

Эдуард (Леший) Погодин в Этномире

Поездка на маз 203.067 C104 355CF

Johnson & Johnson Diaper rash

Чудо Природа.Амрика кут.

Cobbler Legend Multi Pockets Vintage Genuine Leather Bag Female Sm

Крипто новости 14.05 или как Илон Маск манипулирует рынком

Boss levels for Daily Challenge and King Pig Panic 2018-10-25

Dianna Argon

We Got Bibberbanged | Baldur's Gate 3 Funny Moments #baldursgate3

Я не романтик🤍

rocs mascot!

Video | #देहाती_चईता | ले ले आई माज़ा ये राजा | #Ranjeet Singh, #Shilpi Raj | Bhojpuri Song

ГОА . Как доехать из Калангута в Арамболь Бюджетно скоро в Новом Видео #shortsvideo #путешествия

ADN Diabète 2016 - Nutrition de l'enfant diabétique - THEVENIEAU - Aix En Provence FRANCE

Levi and Eren are at again😭(Ft. Annie, Armin, Mikasa and Jean)

Ленин хочет электрический замок!

Drop Site Massacre | Let's Play Warhammer 40k: Gladius Multiplayer W/ Herr Toloko #10

Рибалка на Дністрі(Стара Ушиця) частина 2

Дама - Ночь.

dsl si on m'entent pas

Прогноз по знакам зодиака на 7 ноября

Как купить медиа портфель 1
🍄 TITOUAN vous dévoile les SECRETS de son LABORATOIRE de MYCICULTURE - Épisode 2
За каждым успешным каналом стоит личность, идея и сотни часов кропотливого труда. Если вы здесь, значит, автор «Весёлые опыты с наукой» уже сумел зацепить ваше внимание своим уникальным стилем или подачей. А мы на RUVIDEO позаботились о том, чтобы вы могли изучить весь архив его работ в максимально комфортных условиях — без лишней суеты и преград.
Почему за работами канала «Весёлые опыты с наукой» так интересно наблюдать? Всё просто: это честный контент, который находит отклик в сердцах зрителей. На нашем ресурсе вы можете смотреть онлайн все видео любимого автора бесплатно и в хорошем качестве. Нам важно, чтобы вы видели каждую деталь и слышали каждый нюанс, поэтому мы используем только стабильные плееры из открытых источников Rutube.
Следите за новинками канала, пересматривайте старые шедевры и открывайте для себя новые грани творчества «Весёлые опыты с наукой». Мы постоянно обновляем ленту, чтобы у вас под рукой всегда были самые свежие выпуски. Никаких сложных регистраций — только вы и творчество, которое вдохновляет. Приятного вам путешествия по миру авторского контента на RUVIDEO!
Видео взято из открытых источников Rutube. Если вы правообладатель, обратитесь к первоисточнику.